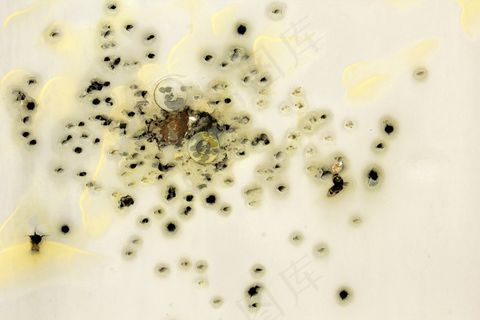
蹩脚的子弹孔平面片

本素材作品名称为绿色,植物,成型,心形,啤酒花,啤酒花,由啤酒花制成的心形,啤酒花心形,素材编号是3490307, 是一张格式为:jpg , 可以使用 常用图片编辑 等软件打开,颜色模式为RGB的作品。 该绿色,植物,成型,心形,啤酒花,啤酒花,由啤酒花制成的心形,啤酒花心形素材模板的大小是 2.47M , 作品尺寸是6000x4000px(5K)像素, 菜鸟图库提供海量共享与原创商用设计素材下载,内容包括: 平面广告素材、电商设计素材、设计UI素材等,下载源文件后可编辑修改文字图片, 免费下载设计素材就来【菜鸟图库】。 本作品绿色,植物,成型,心形,啤酒花,啤酒花,由啤酒花制成的心形,啤酒花心形是由菜鸟图库设计师上传。
本作品授权方式为CC0,可商用,由于本作品由用户上传,平台无法识别信息的准确性,请谨慎使用;所有用户下载和使用我们的图像均需自行承担风险,并对随后的图像使用和应用负全部责任。
版权服务协议
侵权投诉
举报素材